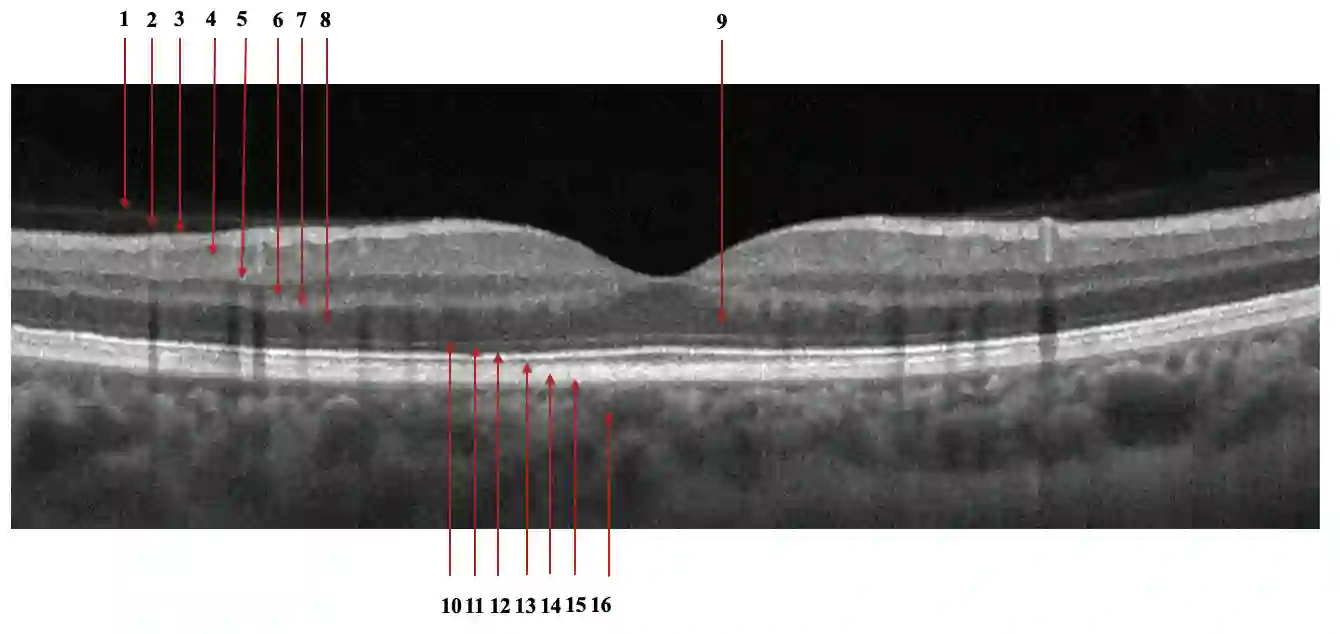
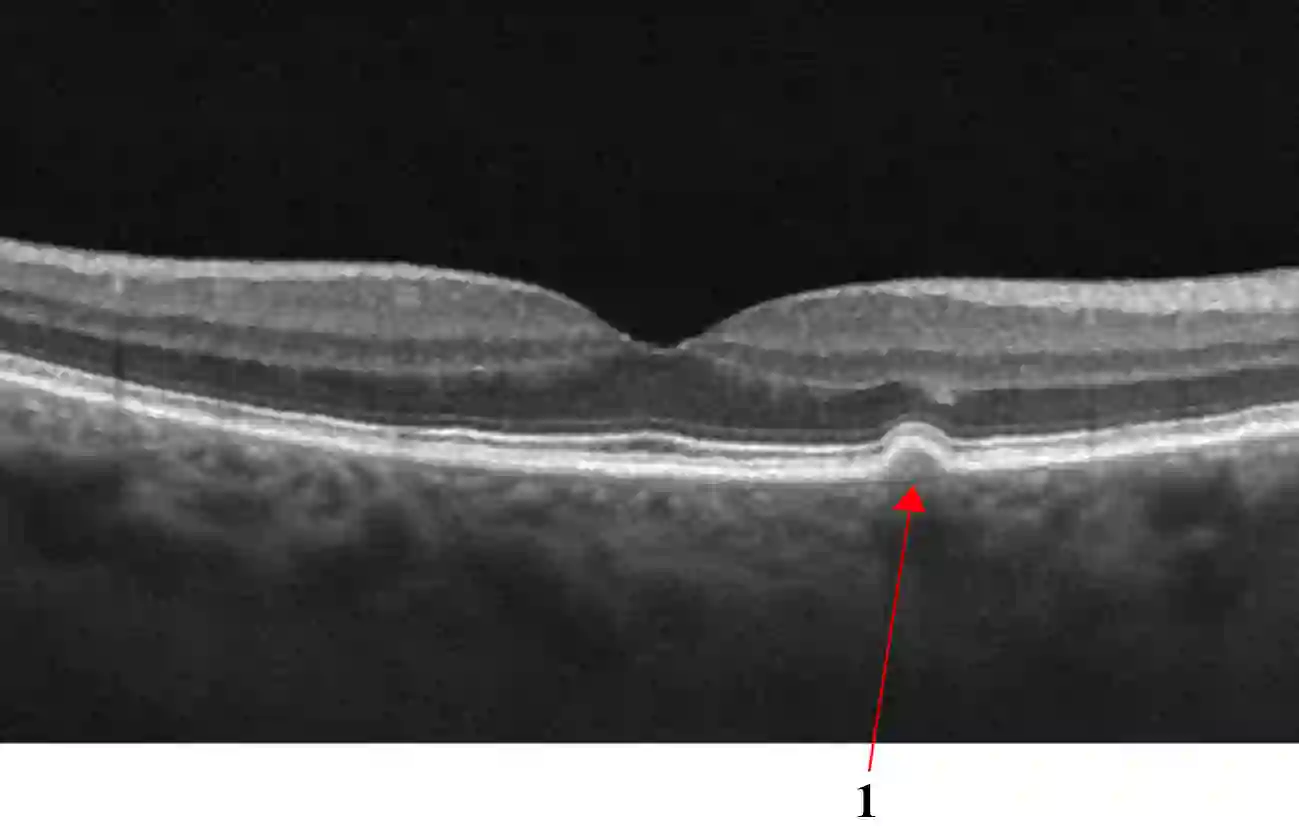
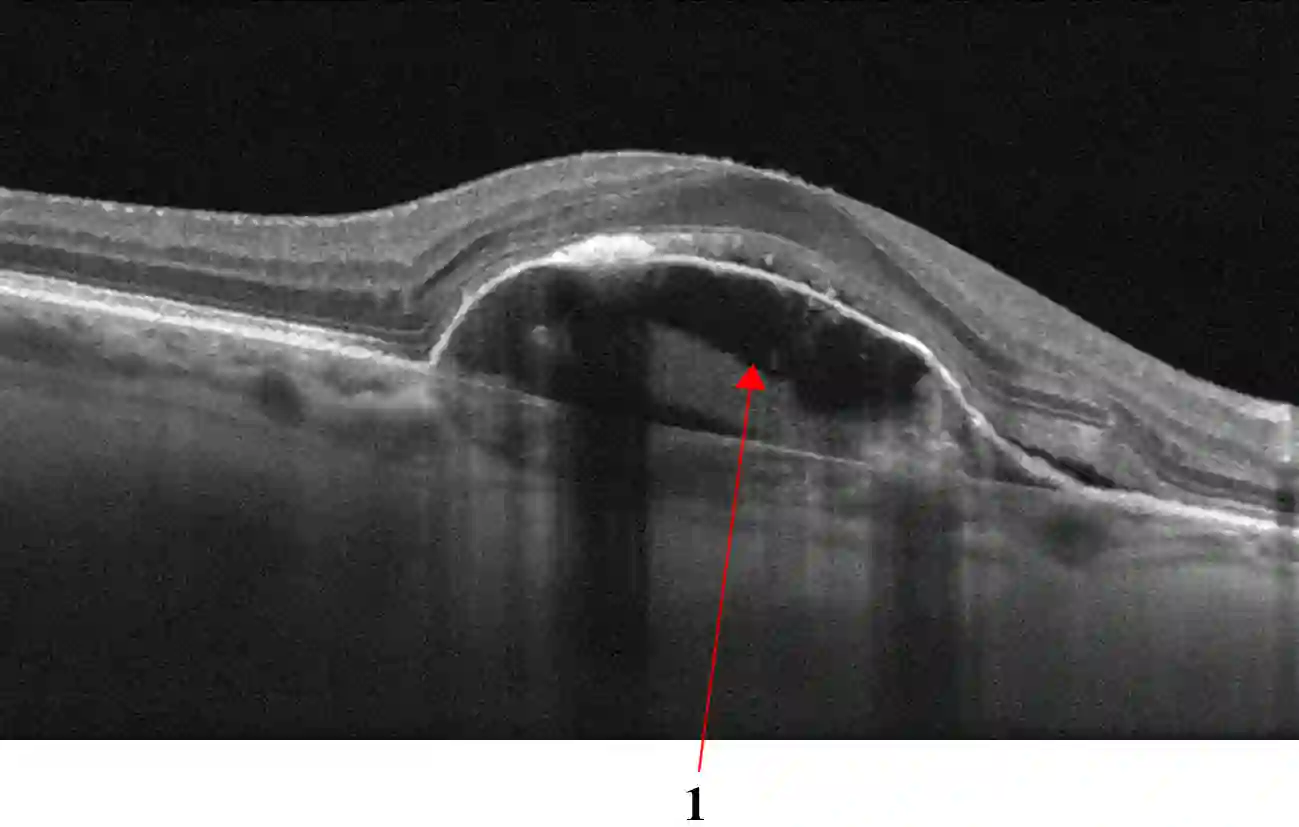

Optical coherence tomography (OCT) is a non-invasive imaging technique with extensive clinical applications in ophthalmology. OCT enables the visualization of the retinal layers, playing a vital role in the early detection and monitoring of retinal diseases. OCT uses the principle of light wave interference to create detailed images of the retinal microstructures, making it a valuable tool for diagnosing ocular conditions. This work presents an open-access OCT dataset (OCTDL) comprising over 1600 high-resolution OCT images labeled according to disease group and retinal pathology. The dataset consists of OCT records of patients with Age-related Macular Degeneration (AMD), Diabetic Macular Edema (DME), Epiretinal Membrane (ERM), Retinal Artery Occlusion (RAO), Retinal Vein Occlusion (RVO), and Vitreomacular Interface Disease (VID). The images were acquired with an Optovue Avanti RTVue XR using raster scanning protocols with dynamic scan length and image resolution. Each retinal b-scan was acquired by centering on the fovea and interpreted and cataloged by an experienced retinal specialist. In this work, we applied Deep Learning classification techniques to this new open-access dataset.
翻译:暂无翻译